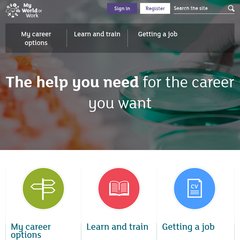

Learndirectscotland.com
Learndirectscotland is ranked 338,601 in the United Kingdom. 'Careers Advice and Jobs in Scotland - My WoW | My World of Work.'
338,601Rank in United Kingdom
--Worldwide Rank
| Monthly pages viewed | < 300 | |
| Monthly visits | < 300 | |
| Value per visitor | £0.46 | |
| Estimated worth | £275.22 | |
| External links | 342 | |
| Number of pages | 11,865 |
Last Updated: 06/04/2018 . Estimated data, read disclaimer.
Content
www.Learndirectscotland.com
Topics: Choose A Career, Career Options, and Get A Job.
Age: The domain is 17 years and 10 months old.
- Popular pages
- learndirectscotland.co.. learndirect scotland - Scotland's learning gateway
- learndirectscotland.co.. Funding Information: Full Time Further Education Parental Income ..
- learndirectscotland.co.. Centre Search
- learndirectscotland.co.. Search
- learndirectscotland.co.. Learning styles
- Links in
- auchmountaincentre.co... Bringing members together for mutual enjoyment and assistance
- intesol.co.uk TESOL / TEFL courses | TESOL / TEFL Certification and INTESOL Training
- eastayrshirellp.org Help at Hand – Help with Reading, Writing and Numbers in East
- moray.ac.uk Moray College - Elgin, Moray, Scotland
- Links out
- scottish-enterprise.co.. Business advice and support for Scotland's growing businesses
- jhptraining.com JHP Group Ltd | JHP Training - Vocational, Apprenticeships, NVQ
- samyeling.org Kagyu Samye Ling - Tibetan Buddhist Centre - Meditation Courses
- glasgow.gov.uk Glasgow City Council Homepage
| Server Location | |
| Atos Origin England London United Kingdom 51.5, -0.12 | |
It is hosted by Atos Origin (England, London,) using Apache web server. Learndirectscotland.com's server IP number is 157.203.39.90. It has 7 nameservers, including ns6.demysdns.co.uk, ns0.demysdns.net, and ns1.demysdns.net.
IP: 157.203.39.90
Web Server: Apache
Encoding: utf-8
Website load time is 2890 milliseconds, slower than 66% of other measured websites.
| Server Setup | |
| Connection: | Keep-Alive |
|---|---|
| Transfer-Encoding: | chunked |
| Expires: | -- |
| Date: | -- |
| Content-Type: | text/html; charset=utf-8 |
| ETag: | "ba042842b33d1b645165bfd9b93eafa6" |
| Server: | Apache |
| Set-Cookie: | -- |
| Last-Modified: | -- |
| Cache-Control: | max-age=1, private, must-revalidate |





